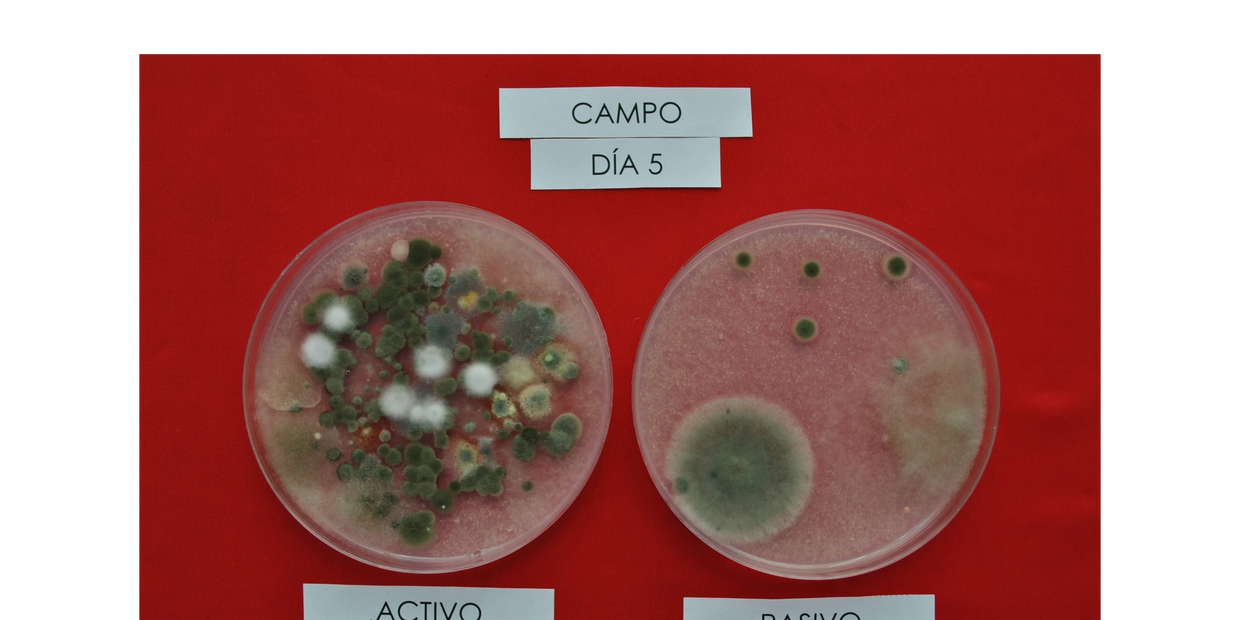

Iniciaste sesión como:
filler@godaddy.com
El monitoreo microbiológico de aire es un procedimiento que permite identificar y cuantificar la carga microbiana ambiental para medir los riesgos de afectación y establecer control preventivo. Los microorganismos que se buscan usualmente son bacterias y hongos como Alternaria, Aspergillus, Botrytis, Cladosporium, Itersonilia, M. polvoso, M. velloso, Penicillium, Stemphylium, otros.
SAVE ejecuta el monitoreo de aire con equipos especializados por impacto de aire sobre un medio de cultivo específico. Así se obtiene una representación real de la calidad microbiológica del ambiente a diferencia de la medición pasiva (por decantación). El método por impacto tiene dos principales ventajas: Primera, poder relacionar el volumen de aire con la cantidad de microrganismos capturados, lo cual no es posible en el método pasivo dado que el volumen de aire es incierto y depende de la turbulencia natural del aire. Segunda, el muestreo microbiológico de aire por impacto es 100% repetible y por ende comparable.
En agricultura, se recomienda monitorear en invernaderos, cuartos fríos y salas de postcosecha para salvaguardar la calidad del producto final.
Ejemplo de esto son las condiciones de producción y empaque de insumos farmacéuticos, el empaque de alimentos, los laboratorios de microbiología, el almacenamiento de semillas, almacenamiento de productos agrícolas derivados del cannabis, salas de poscosecha de cultivos de flores, áreas de cultivo bajo invernadero. Para algunos procesos existe reglamentación en cuanto a los máxima carga ambiental permitida para ciertos microorganismos. Sin embargo, independiente de que exista una reglamentación, es claro que existe una estrecha relación entre la calidad final de un producto y las condiciones ambientales en que este se realiza.
En la producción agrícola las estructuras de patógenos foliares, como Botrytis cinérea, se liberan al ambiente en grandes volúmenes y representan una amenaza para el cultivo. Predecir esta condición a través de un monitoreo ambiental por impacto, permite tomar medidas oportunas de control para mantener la calidad final del producto cosechado y minimizar pérdidas económicas.
Para el monitoreo de aire, se debe definir el área a estudiar y los microorganismos objetivo. Con base en esto, se traza el plan de muestreo que define la cantidad de puntos de monitoreo y la ubicación de los mismos en el área.
Es recomendable tomar un muestreo ambiental inicial para conocer el estado del cuál se parte. Los resultados de este monitoreo mostrarán el nivel de infestación con el cual se trazará el plan de acción adecuado.
Una vez se haya ejecutado el plan de acción, es recomendable tomar el muestreo final en las mismas condiciones que el inicial para evidenciar los efectos de la corrección.
Para obtener más información sobre el monitoreo microbiológico de aire con equipos de impacto
Abre hoy | 07:00 a. m. – 05:00 p. m. |

Escanea este código para agregarnos a tus contactos.
Copyright © 2020 Save Consultores SAS - Todos los derechos reservados.
Tomate
CMV, INSV, POTY, TMV, TAV TBSV, ToRSV, TSWV
Cannabis
ArMV, CMV, POTY, TMV, TSV, ToRSV, TSWV
Alstroemeria, crisantemo, clavel, statice
AlCV, AIMV, BBWV, CaRMV, CBV, CMV, CNFV, CVMV, INSV, LSV, POTY, TSWV,
Viroides en papa
Esta página web utiliza cookies. Al seguir utilizando esta página, aceptas nuestro uso de cookies.